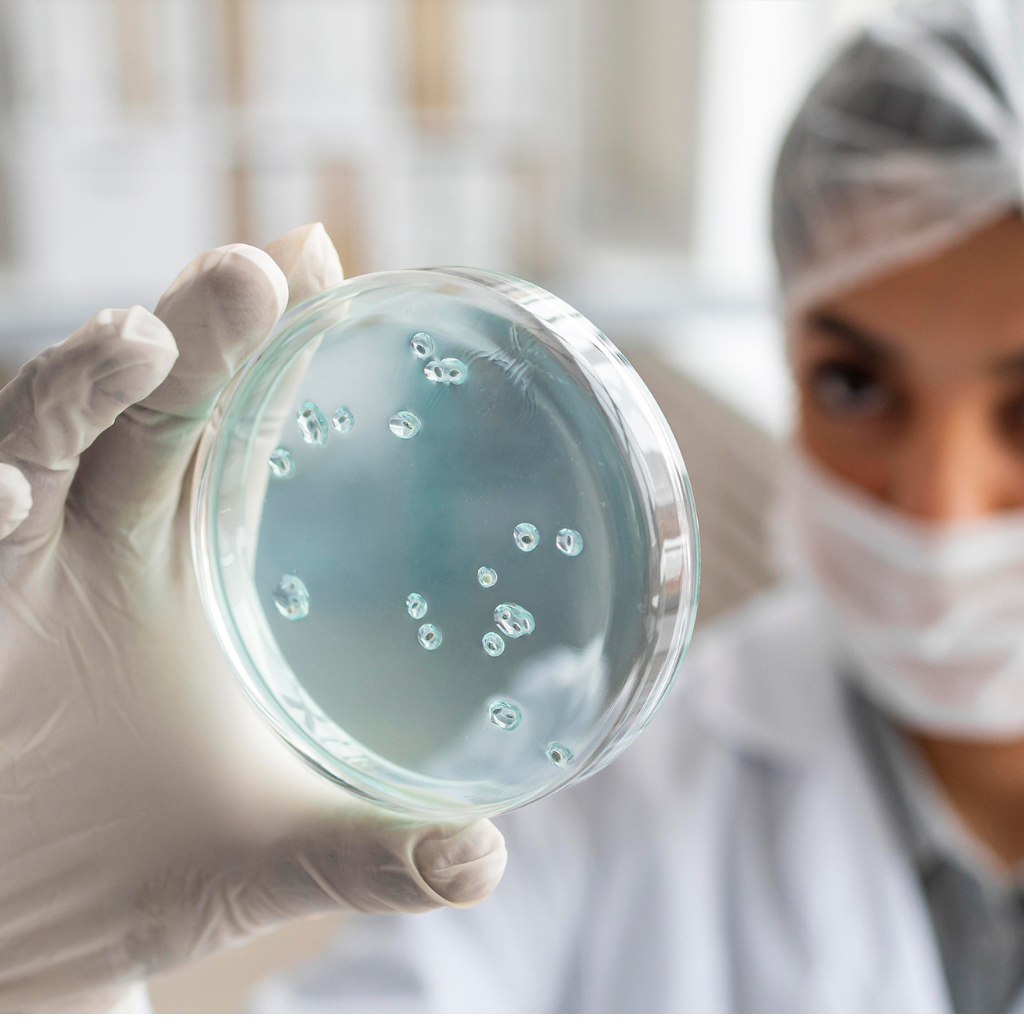
collection-img
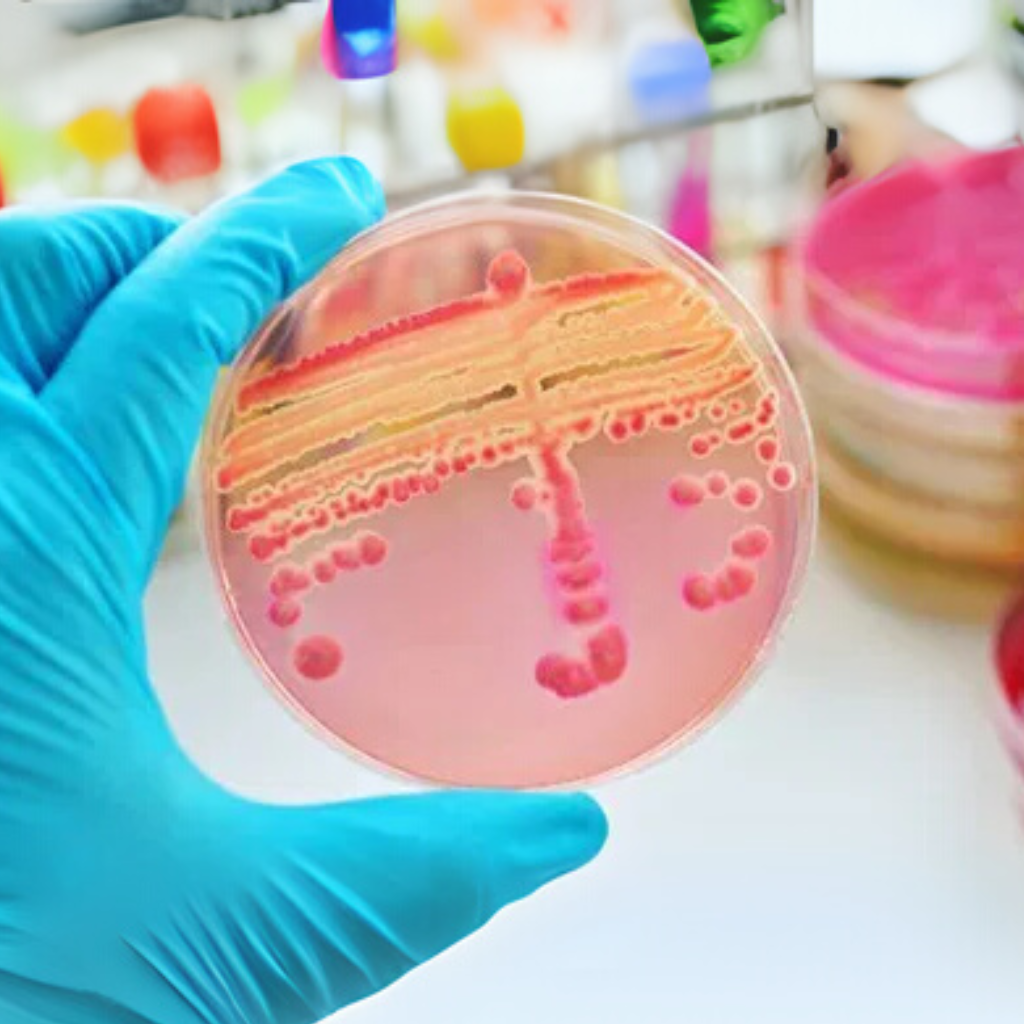
collection-img

-
Entrega nacional
Entregamos em todo território nacional
Economia
Economize em cada pedido
Suporte
Suporte especializado
Devolução de dinheiro
Cancele o pedido a qualquer momento
Categorias
Bioquímica / Turbidimetria
- 57 Itens -
Testes Rápidos
- 49 Itens -
Hematologia
- 29 Itens -
Equipamentos
- 18 Itens -
EPIs
- 11 Itens -
Coleta de Sangue
- 64 Itens -
Imuno-Hematologia
- 15 Itens -
Imunologia
- 12 Itens -
Microbiologia
- 170 Itens -
Mais vendidos
-
DescarpackPreço normal R$ 16,22 --87%
R$ 8,68Preço normal R$ 16,22HightopPreço normal R$ 67,50 --47%R$ 45,97Preço normal R$ 67,50
-
CeconPreço normal R$ 21,60 -Liquid error (snippets/product-price-listing line 25): Computation results in '-Infinity'%Preço normal R$ 21,60CeconPreço normal R$ 21,60 -Liquid error (snippets/product-price-listing line 25): Computation results in '-Infinity'%Preço normal R$ 21,60
-
RenylabPreço normal R$ 22,95 -Liquid error (snippets/product-price-listing line 25): Computation results in '-Infinity'%
R$ 0,00Preço normal R$ 22,95VixtalPreço normal R$ 126,90 -Liquid error (snippets/product-price-listing line 25): Computation results in '-Infinity'%R$ 0,00Preço normal R$ 126,90
-
BioconPreço normal R$ 267,30 --26%
R$ 211,76Preço normal R$ 267,30WondfoPreço normal R$ 97,20 -Liquid error (snippets/product-price-listing line 25): Computation results in '-Infinity'%Preço normal R$ 97,20
-
NewprovPreço normal R$ 59,47 -Liquid error (snippets/product-price-listing line 25): Computation results in '-Infinity'%Preço normal R$ 59,47CeconPreço normal R$ 24,96 -Liquid error (snippets/product-price-listing line 25): Computation results in '-Infinity'%Preço normal R$ 24,96
Ao continuar a usar este site, você concorda com a Política de Privacidade